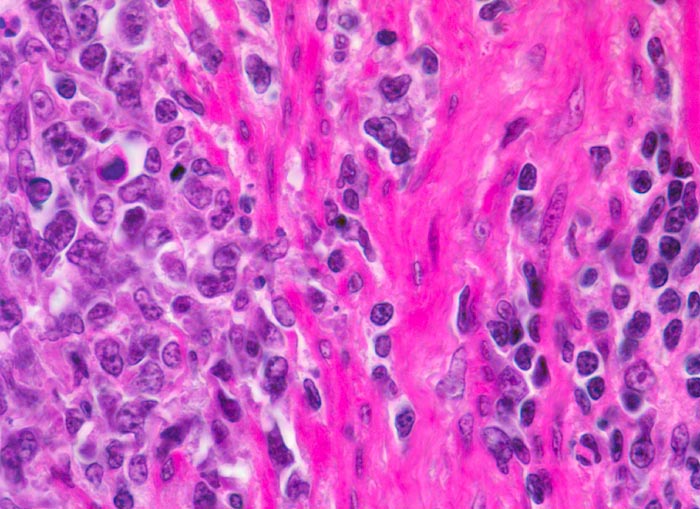

PathoPic – image database / PathoPic ID 3331 - extranodales Marginalzonenlymphom vom MALT-Typ mit Transformation
de
Diagnose
extranodales Marginalzonenlymphom vom MALT-Typ mit Transformation
Diagnose Gruppe
maligner Tumor
Topographie
Magenantrum
Topographie Gruppe
Oesophagus, Magen
Beschreibung
Rechts im Bild das kleinzellige Infiltrat des MALT Lymphoms. Links im Bild ein Blastenrasen.
Kommentar
Extranodale MALT Lymphome des Magens können sekundär transformieren in ein diffuses grosszelliges B-Zell Lymphom. Dieses ist definiert als mehr als 10% Blasten, bzw. Anwesenheit eines Clusters von mehr als 20 Blasten oder Blastenrasen neben kleinzelliger MALT Lymphom Komponente.
Bilder Typ
Histologie
Alter
67
Geschlecht
männlich
Datum
Ersteintrag: 12.11.2001